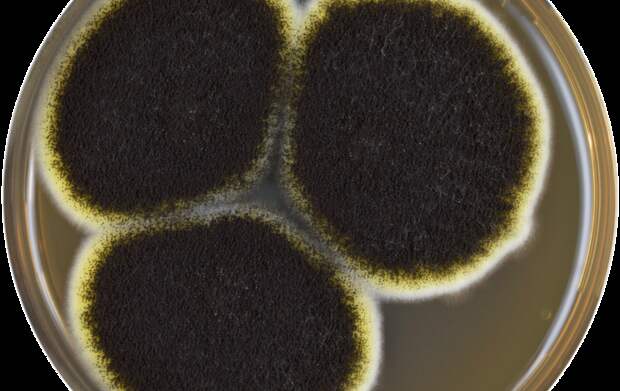

Споры плесени Aspergillus niger способны выжить на поверхности Марса, выяснила международная группа ученых при участии специалистов NASA и Института аэрокосмической медицины в Германии. Исследование было опубликовано в журнале Frontiers in Microbiology. Для эксперимента ученые использовали воздушный шар, который в течение нескольких часов находился в стратосфере, в 38 км от поверхности Земли - радиационная обстановка, по словам исследователей, на этой высоте примерно такая же, что и на поверхности Марса и в нижних слоях его атмосферы.
К шару они прикрепили установку MARSBOx, в которой находились образцы бактерий Salinisphaera shabanensis, Staphylococcus capitis и Buttiauxella и плесневый грибок Aspergillus niger. Образцы располагались в два слоя, нижний из которых был экранирован от космического излучения - это позволило отделить воздействие радиации от других факторов.
Все микроорганизмы пострадали в той или иной степени. Наиболее живучей оказалась плесень - ученым удалось восстановить ее после возвращения на Землю.
Черная плесень способна приводить к поражениям дыхательных путей - впрочем, это касается преимущественно людей с иммунодефицитами. В целом, однако, стоит иметь в виду, что она может пережить полет на Марс, и учитывать это при подготовке экспедиций.
Свежие комментарии